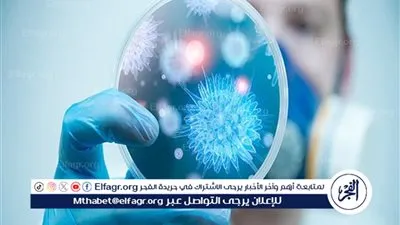
فيروس جديد يثير القلق: حالة طوارئ صحية عالمية

عاجل
مادلين طبر: أحرص على قضاء رمضان في مصر.. وأحمل المصحف معي وأقرأ القرآن رغم ديانتي المسيحية
“الست موناليزا” تكتسح تريند جوجل… حلقة 12 تقلب الموازين ومي عمر تتوهج في رمضان 2026
د.حماد عبدالله يكتب: موالد " المثقفين " !!
ليلة طرب في الشيخ زايد.. محمد عدوية يحيي سهرة رمضانية ويُشعل الأجواء بأغانيه وأعمال والده الأسطورة
رحيل ماجد حسني يهز الوسط الفني… ونجوم الفن يودعونه بكلمات مؤثرة